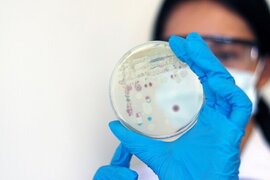
.

Dünyada xəbərlər
Trampdan Putin-Zelenski görüşü barədə ŞOK ETİRAF
ABŞ Prezidenti Donald Tramp etiraf edib ki, Putin və Zelenski arasında mümkün görüş istənilən nəticəni verməyə bilər. xəbər verir ki, o, bu barədə Ağ Evdə çıxışı zamanı bildirib. ABŞ lideri sözügedən görüşdə iştirakının mümkün olduğunu da qeyd edib. Tramp vurğulayıb ki, o, iki həftə ərzində Ukrayna ətrafınd
24 avqust
Qəzzada aclıqdan ölənlərin sayı 281-ə çatıb, 114-ü uşaqdır
Qəzzanın blokadası zamanı qida çatışmazlığından ölənlərin ümumi sayı 114-ü uşaq olmaqla, 281 nəfərə çatıb. "Report" xəbəe verir ki, bu barədə Fələstin Səhiyyə Nazirliyi məlumat yayıb. "Son 24 saat ərzində ikisi uşaq olmaqla, aclıq və qida çatışmazlığından səkkiz ölüm faktını qeydə alıb
24 avqust
Ukrayna Rusiyaya qarşı sanksiyalar siyahısını genişləndirib
Ukrayna Prezidenti Volodimir Zelenski Rusiya və onu dəstəkləyənlərə qarşı sanksiya tətbiq edilməsi haqqında fərmanı imzalayıb. xəbər verir ki, bu barədə Ukrayna prezidenti özünün "Telegram" kanalında yazıb. "Sanksiya tətbiqini davam etdiririk. Bu gün iki fərman imzaladım. Birincisi, Ukraynad
24 avqust
İsrail hərbçiləri Qəzzada mövqelərini möhkəmləndirir
İsrail ordusu Qəzza şəhərində mövqelərini möhkəmləndirir. "Report" xarici KİV-ə istinadən xəbər verir ki, İsrail tankları Qəzzanın daha bir rayonuna - Sabraya daxil olub. Bu həftənin əvvəlində Zeytun rayonunda İsrail ordusunun zirehli texnikası görünüb. Bundan əvvəl ordunun Qəzza şəhərini
24 avqust
Lukaşenko: "Zəngəzur dəhlizinə heç kim müqavimət göstərə bilməz"
Belarus Prezidenti Aleksandr Lukaşenko ABŞ-li həmkarı Donald Trampı Ermənistan və Azərbaycan arasında vəziyyətin uğurla nizamlanmasına görə təbrik edib. "Belta"ya istinadən xəbər verir ki, bu barədə Lukaşenko jurnalistlərin suallarını cavablandırarkən bildirib. O, ABŞ prezidenti ilə telefo
24 avqust
ChatGPT-nin məsləhəti ilə səyahətə çıxdı, rəzil oldu
Neyroşəbəkələr getdikcə gündəlik həyatımıza daxil olur. Xüsusilə də, daha çox insan xaricə səyahət planlaşdırarkən ChatGPT və ya onun analoqları ilə məsləhətləşir. Ancaq burada diqqətli olmaq lazımdır. xəbər verir ki, təcrübəli səyahətçi Vinisius Koşta turistlərə bu barədə xəbərdarlıq edib. O bildiri
24 avqust
Narendra Modi: Hindistanın əvvəlki hökumətləri texnologiya və sənaye fürsətlərini əldən buraxıb
Hindistan 2014-cü ildən bəri heç bir fürsəti qaçırmamağı seçdi. "Report" "Times of İndia"ya istinadən xəbər verir ki, bunu "The Economic Times World Leaders" Forumunda çıxış edən Hindistanın Baş naziri Narendra Modi deyib. N.Modi özündən əvvəlki hökuməti tənqid edərək onları
24 avqust
İranda antiterror əməliyyatı keçirilib, 6 nəfər zərərsizləşdirilib
İran kəşfiyyatı ölkənin cənub-şərqindəki Sistan və Bəlucistan əyalətində terrorçu qrupu zərərsizləşdirib. "Report" bu barəfə "Mehr" agentliyinə istinadən xəbər verir. Bildirilib ki, döyüş sursatı ilə silahlanmış qeyri-İran vətəndaşları ilə kəşfiyyat qüvvələri arasında saatlarla dava
24 avqust
BAEA-nın rəhbəri İranda həbs oluna bilər
İran Beynəlxalq Atom Enerjisi Agentliyinin baş direktoru Rafael Qrossini Tehrana səfəri zamanı həbs etməklə hədələyib. xəbər verir ki, bu barədə "Azad İran" məlumat yayıb. Bildirilib ki, Qrossinin BMT-nin Baş Katibliyinə namizəd olacağı ehtimalı var və İran bunu onu tənqid etmək üçün bəhan
24 avqust
KİV: Nigeriya HHQ Kamerun sərhədi yaxınlığında 35 silahlını məhv edib
Nigeriya Hərbi Hava Qüvvələri (HHQ) Kamerunla sərhədə endirdiyi hava hücumlarında azı 35 silahlını məhv edib. "Report" xəbər verir ki, bu barədə "Reuters" Nigeriya Hərbi Hava Qüvvələrinin sözçüsü Ehimen Ejodame istinadən məlumat yayıb. Məlumata görə, HHQ qruplaşmanın quru qoşunların
24 avqust
Tehranda 7,2 bal gücündə zəlzələ gözlənilir?
İranın paytaxtı Tehranın şimalındakı fay xətti Rixter cədvəli üzrə 7,2 bal gücündə zəlzələyə səbəb ola bilər. "Azad İran" "Telegram" kanalına istinadən xəbər verir ki, bu barədə ölkənin Böhranın Qarşısının Alınması və İdarə Edilməsi Təşkilatının rəhbəri Əli Nəsiri bildirib. İran rəsmis
24 avqust
Tatarıstanın Rəisi Rusiyada miqrantaların uşaqları ilə bağlı qoyulan qadağanı axmaqlıq adlandırıb
Rusiya Federasiyasının Tatarıstan Respublikasının Rəisi Rüstəm Minnixanov rus dilini bilməyən miqrantların uşaqlarının məktəbə qəbulunu qadağan edən qanunu tənqid edib. "Report"un məlumatına görə, İnnopolisdə (Tatarıstanın paytaxtı Kazan yaxınlığındakı şəhər – Qeyd) respublika pedaqoji şuranı
24 avqust
Tramp Epşteyn işinin fayllarının Konqresə təhvil verməsini dəstəkləyib
ABŞ prezidenti Donald Tramp uşaqlara təcavüz və bu qəbildən olan digər ağır cinayətlərdə təqsirli bilinən maliyyəçi Cefri Epşteynin işi ilə bağlı materialların ABŞ Ədliyyə Nazirliyi tərəfindən Konqresə təqdim edilməsini dəstəkləyib. "Report" xəbər verir ki, bu barədə Vaşinqton administrasiyasını
24 avqust
"Andromeda" yelkənli gəmisi və dörd dalğıc: "Şimal axını"nın partladılması ilə bağlı TƏFƏRRÜAT
"Şimal axını"nın hər iki qaz kəməri ən azı dörd partlayıcı qurğu ilə sıradan çıxarılıb. -ın məlumatına görə, bu barədə SVT əldə etdiyi sənədlərə əsasən xəbər yayıb. Alman istintaqçılarının versiyasına görə, bu qurğular taymerlərlə təchiz edilərək "Andromeda" adlı yelkənli gəmi vasitəsil
24 avqust
16 qətl törədən ən məşhur "killer" həbsxanada vərəmə yoluxdu
Rusiyada "Orexov" qruplaşmasının əsas "killer"i, 16 qətl törətdiyinə görə həbsdə olan İqor Sosnovski müalicə-islahedici müəssisəyə köçürülüb. Məlumata görə, köçürülmənin səbəbi vərəm olub. yerli mediaya istinadla bildirir ki, "Çipit" ləqəbi ilə tanınan ən məşhur "killer"lərdə
24 avqust
Putin Trampla Alyaskadakı görüşünü çox yaxşı adlandırıb
Rusiya prezidenti Vladimir Putin amerikalı həmkarı Donald Trampla Alyaskada görüşün çox yaxşı keçdiyi qənaətindədir. "Report" xəbər verir ki, bu barədə Putin nüvə sənayesi işçiləri ilə görüşündə danışıb. "Alyaskada çox yaxşı, mənalı və səmimi görüş keçirdik", - Putin bildirib
24 avqust
Bu ölkədə 400 dəvəquşu öldürüləcək
Kanadada Britaniya Kolumbiyasında yerləşən bir fermada təxminən 400 dəvəquşu məhv ediləcək. Bu qərar apellyasiya məhkəməsinin əvvəlki hökmü qüvvədə saxlamasından sonra qəbul olunub. xarici mediaya istinadla bildirir ki, qərar ötən il fermada baş verən quş qripi epidemiyası ilə bağlıdır. Hadisə nəticəsind
24 avqust
ABŞ rəsmiləri enerji şirkətlərinə 20 ton plutonium vermək istəyir
Vaşinqton administrasiyası Amerika enerji şirkətlərinə nüvə stansiyalarında yanacaq kimi mümkün istifadə üçün əvvəllər utilizasiya olunmuş nüvə başlıqlarından təxminən 20 ton plutonium vermək niyyətindədir. "Report"un məlumatına görə, bu barədə mənbələrə istinadən "Reuters" məluma
24 avqust
Vens Boltonun evində axtarışların Trampın tənqidi ilə əlaqəli olduğunu təkzib edib
ABŞ Prezidenti Donald Trampın keçmiş milli təhlükəsizlik müşaviri Con Boltonun evində və ofisində aparılan axtarışlar onun hazırkı Amerika liderini tənqid etməsi ilə bağlı deyil. "Report"un məlumatına görə, bunu ABŞ-nin vitse-prezidenti Cey Di Vens NBC telekanalına müsahibəsində deyib. Ven
24 avqust
Dünyada ilk qocalar evi İsraildə olub
Hayfa Universitetinin arxeoloqları Qalileya dənizi yaxınlığında apardıqları qazıntılar zamanı yunan dilində "Yaşlılara dinclik" sözlərinin yazıldığı mozaika paneli aşkarlayıblar. "Israel National News"a istinadən xəbər verir ki, bu tapıntı İsraildə ilk qocalar evinin mövcud olduğun
24 avqust
Toydan 9 gün sonra hamilə arvadını öldürüb özünü çaya atdı
Rusiyada 24 yaşlı gənc toyundan cəmi 9 gün sonra hamilə arvadının həyatına son qoyub. yerli telegram kanallarına istinadla bildirir ki, istintaqın versiyasına görə, ər-arvad 17 avqust axşamı kirayə mənzildə içki içiblər. Bir anda qısqanclıq zəminində mübahisə başlayıb. Ər arvadının boğazından tutara
24 avqust
KİV: ABŞ maliyyə nazirinin müavini Trampın fikirlərini bölüşmədiyi üçün istefa verib
Maliyyə nazirinin müavini Maykl Folkender ABŞ prezidenti Donald Trampın fikirlərini bölüşmədiyi üçün vəzifəsini tərk edib. "Report" xəbər verir ki, bu barədə "The Wall Street Journal" mənbələrə istinadən məlumat yayıb. Qeyd olunub ki, Amerika liderinin narazılığının səbəblərində
24 avqust
ABŞ-də "ət yeyən" bakteriyaya yoluxma hallarının sayı artıb
ABŞ-nin sahilyanı bölgələrində "ət yeyən" kimi təsnif edilən "Vibrio vulnificus" bakteriyasına yoluxma hallarının sayı artıb. "Report" xəbər verir ki, bu barədə "Tribuna" məlumat yayıb. ABŞ Xəstəliklərə Nəzarət və Qarşısının Alınması Mərkəzlərinin məlumatına görə
24 avqust
"Ayının parçaladığı" kişinin qatili oğlu çıxdı
Yaponiyada 93 yaşlı kişi əvvəlcə ayı hücumunun qurbanı hesab olunsa da, sonradan məlum olub ki, onu əslində öz oğlu öldürüb. İstintaqdan sonra polis 51 yaşlı Fudziyuki Şindonu atasını qətlə yetirməkdə şübhəli bilərək həbs edib. xarici KİV-ə istinadla bildirir ki, Yaponiyanın şimalındakı Akita prefekturasınd
24 avqust
Rusiyada 11 yeni istintaq təcridxanası yaradılacaq
Rusiyada son 5 ildə bəzi regionlarda limitin aşılması ilə əlaqədar yeni istintaq təcridxanaları yaradılacaq. "Report" xəbər verir ki, bu barədə Rusiya hökumətinin qərarında deyilir. Sənəddə bildirilib ki, 11,23 min yerlik 11 yeni istintaq təcridxanasının, 3,42 min yerlik 14 mühafizə binasını
24 avqust
ABŞ "Intel" şirkətində pulsuz 10 faizlik paya sahib olub
Prezident Donald Trampın bağladığı yeni müqaviləyə əsasən, Birləşmiş Ştatlar "Intel" şirkətində 10% paya malik olacaq. -ın xəbərinə görə, bu barədə Ağ Ev rəhbəri "Truth Social" platformasında yazaraq, səhmlərin ABŞ-yə pulsuz çatdığını qeyd edib. "Mən bu sövdələşmə barədə şirkəti
24 avqust
ABŞ-yə tədarük edilən mebellərə rüsumlar tətbiq oluna bilər
Vaşinqton administrasiyası digər ölkələrdən ABŞ-yə mebel tədarükü ilə bağlı araşdırma aparır və araşdırmadan sonra bu məhsullara rüsumlar tətbiq olunacaq. "Report"un xəbərinə görə, bu barədə ABŞ Prezidenti Donald Tramp "Truth Social"da məlumat verib. Onun sözlərinə görə, hakimiyyə
24 avqust
ABŞ prezidentinin Ukrayna üzrə xüsusi nümayəndəsi Kiyevə səfər edəcək
ABŞ prezidentinin Ukrayna üzrə xüsusi nümayəndəsi Kit Kelloq avqustun 23-də Kiyevə səfər edəcək. -ın məlumatına görə, bu barədə Ağ Evin müxbiri Qrem Sletteri özünün "X" hesabında xəbər verib. Məlumata görə, Kelloqun səfərinin məqsədi Kiyevdə Milli Dua Ziyafətinə qatılmaq və avqustun 24-də keçiriləcə
24 avqust
Kral ailəsində qadağan olunan QİDALAR
Krallıq ailəsində qidalanma onların həyatının digər sahələri kimi az qala eyni dərəcədə sərt qaydalarla tənzimlənir. Monarxlar üçün yalnız nəyin yeyilə biləcəyi deyil, həm də yeməyin necə təqdim olunmalı olduğu, hansı məhsulların məqbul sayıldığı, hansılarının isə qəti şəkildə qadağan olunduğu barəd
24 avqust
Rusiyalı alpinist həyat yoldaşının 4 il əvvəl öldüyü yüksəklikdə vəfat edib
Rusiyalı alpinist Natalya Naqovitsina Qırğızıstanın Pobeda zirvəsində vəfat edib. "Report" "SHOT" teleqram kanalına istinadən xəbər verir ki, idmançı zirvədən enərkən ayağını sındırıb və bir həftədən çox 700 metr yüksəklikdə köməksiz vəziyyətdə qalıb. Dağda yeməksiz, susuz qalan 4
24 avqust
Prezident bu şəxsləri təltif etdi (SİYAHI)
Səhər yeməyini ötürsək nə baş verər?
Meyxanaçı Kərim vəfat etdi
Pul boşa gedir: Bu beş smartfonu alanlar peşman olur
"Hazırda "bomj" kimi bir həyat yaşayıram..."
Tanınmış kosmetoloq Natavan Əmirova paylaşımı ilə özünü biabır edib
Nazirdən iki təyinat
Zərgər gətirilən bir çanta qızılı qəbul etmədi: "Bu günaha girə bilmərəm"
Aysundan Rəqsanəyə İRAD: "Səhv deyirsən" - VİDEO
Çində günəş elektrik stansiyası səhranı "oyandırdı" - Alimlər
"Qoç ət"in dönərindən 20 sm tük çıxıb? - "Əməkdaşlarımız saçı qısa olan kişilərdir"
Ölkə başçısının növbəti humanist addımı
Həyat yoldaşına qaraciyərini bağışladı: "Canım idi, ciyərim oldu"
Şagirdlərin saqqızdan zəhərlənməsi iddiaları ilə bağlı - Açıqlama - Fotolar
Kərim harda dəfn olunacaq? (AÇIQLAMA)
